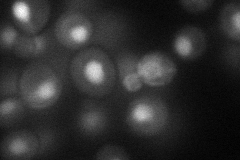
YDL175C
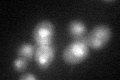
YDL175C
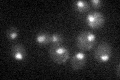
YDL175C

View description
Zinc knuckle protein, involved in nuclear RNA processing and degredation as a component of the TRAMP complex; stimulates the poly(A) polymerase activity of Pap2p in vitro; functionally redundant with Air1p
Localization:
Intensity:
Fold change:
Significance:
-
C’ GFP library in SD

nucleus26.96 -
N' NOP1pr-GFP in SD
nucleus42.9417 -
N' TEF2pr-mCherry in SD

nucleus17.6966 -
N' NATIVEpr-GFP in SD

nucleus28.5122 -
N' TEF2pr-VC and Cyto-VN in SD

nucleus26.5556 -
C’ GFP library in SD+DTT
nucleus25.110.93No -
C’ GFP library in SD+H2O2

nucleus25.180.93No -
C’ GFP library in Starvation Media
nucleus24.970.92No -
C’ GFP library on the background of Pup2-DaMP

nucleus -
C’ GFP library on the background of CCT mutant

nucleus28.3061.04983No
